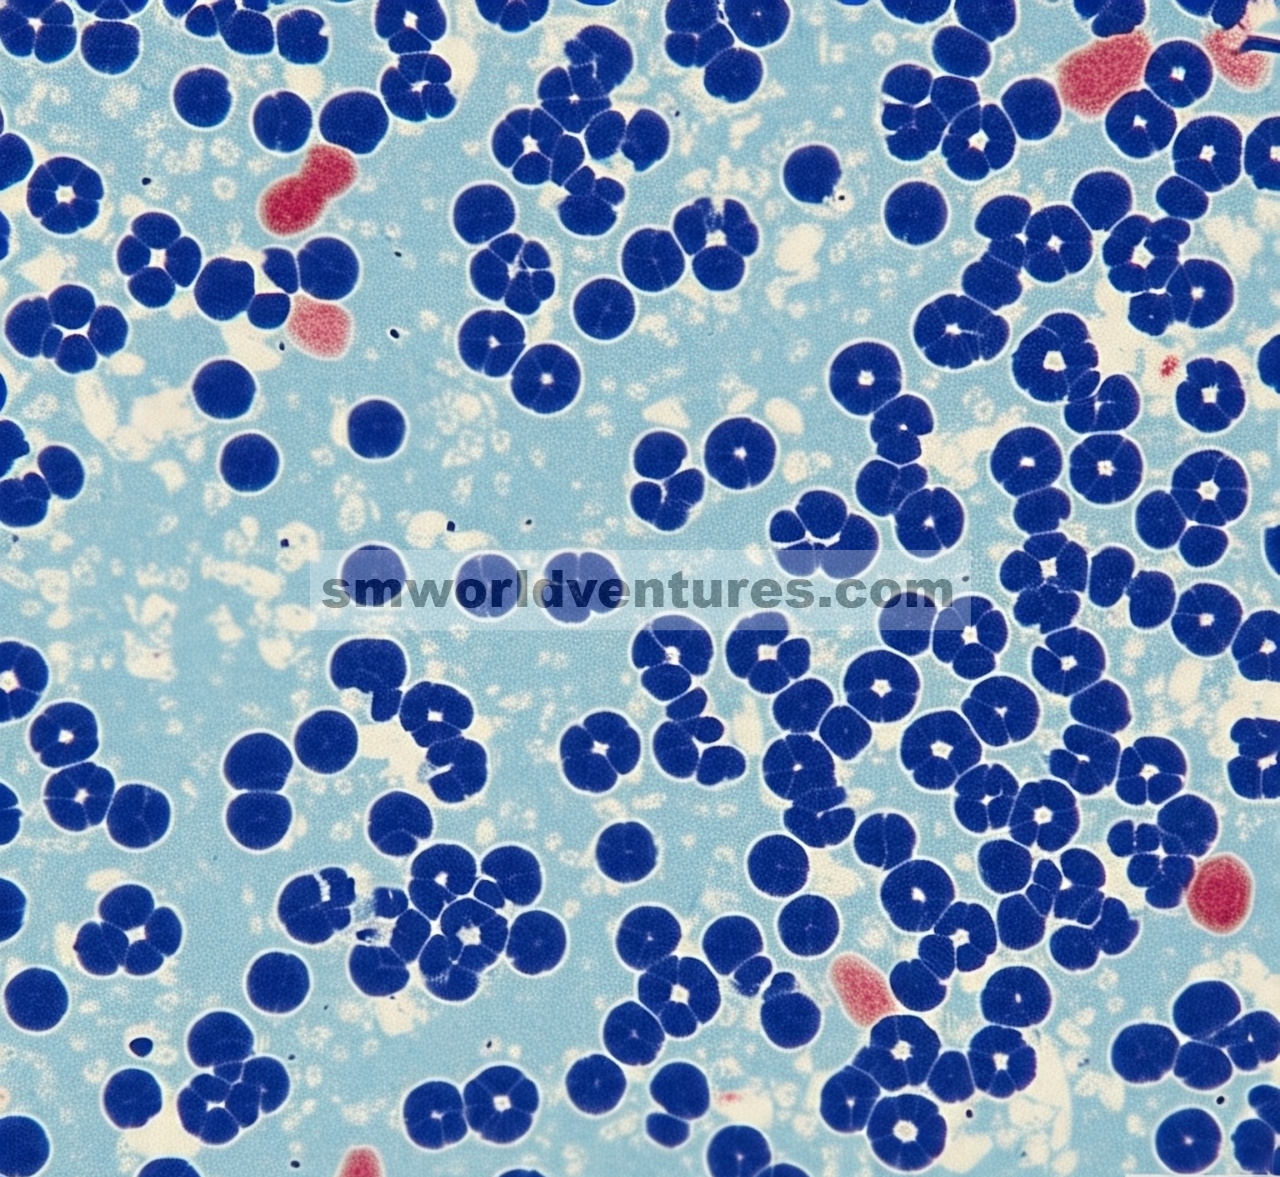
Distribusi subseluler protein pengikat Y-box terfosforilasi-1 di S102 pada pasien kanker kolorektal, dikelompokkan berdasarkan status mutasi KRAS dan fitur klinikopatologis

Abstrak
Onkoprotein Y-box-binding protein-1 (YB-1) terlibat dalam semua ciri khas kanker. Salah satu modifikasi pascatranslasi YB-1 yang paling banyak dipelajari adalah fosforilasi pada Serine 102 (S102), yang terlibat dalam perkembangan kanker. Mutasi KRAS sering terjadi, telah dikaitkan dengan prognosis yang buruk dan resistensi terapi, dan dianggap sebagai stimulator utama S102 YB-1 in vitro . Dalam penelitian ini, hubungan antara fosforilasi S102 YB-1 dalam fraksi subseluler dan mutasi KRAS diselidiki dalam jaringan CRC, dan hubungannya dengan parameter klinikopatologis dianalisis. Imunohistokimia pada 36 sampel pasien dan 5 sampel jaringan normal menyoroti S102 YB-1 nuklir yang spesifik untuk jaringan kanker. S102 YB-1 nuklir diekspresikan dalam 47,2% jaringan tumor, yang berkorelasi positif dengan mutasi KRAS ( P = 0,017). Tidak ada hubungan signifikan antara S102 YB-1 sitoplasma dengan status mutasi KRAS ( P = 0,391). Penelitian lebih lanjut dalam kelompok yang lebih besar diperlukan untuk memvalidasi hasil yang diamati. Hubungan signifikan antara S102 YB-1 dalam nukleus dan mutasi KRAS dapat menunjukkan YB-1 sebagai target yang efektif untuk meningkatkan kelangsungan hidup pasien CRC dengan tumor bermutasi KRAS.
Singkatan
5-FU
5-fluorourasil
BERTINDAK
AKT serin/treonin kinase
BRAF
Proto-Onkogen B-Raf, Serin/Treonin Kinase
CRC
kanker kolorektal
CRT
kemoradioterapi
CT
kemoterapi
Bahasa Indonesia: EGFR
reseptor faktor pertumbuhan epidermal
ERK
kinase yang diatur oleh sinyal ekstraseluler
Bahasa Indonesia: FBXW7
F-box dan WD mengulang domain yang berisi 7
FFPE
difiksasi dengan formalin, dibenamkan dalam parafin
FOLFIRI
5-fluorouracil + leucovorin + irinotecan (rejimen kemoterapi)
G2 dan G3
Tumor Grade 2 (berdiferensiasi sedang)/Grade 3 (berdiferensiasi buruk)
DIA
hematoksilin dan eosin
Posyandu
imunohistokimia
KRIS
Homolog Onkogen Virus Sarkoma Tikus Kirsten
LVI
invasi limfovaskular
M
metastasis (komponen stadium metastasis jauh)
PETA
mitogen-activated protein kinase
MDR1/ABCB1
protein resistensi multi-obat 1/kaset pengikat ATP subfamili B anggota 1
MSI
ketidakstabilan mikrosatelit
MSS
mikrosatelit stabil
Pemain terbaik
protein kubah utama
N
node (komponen stadium keterlibatan kelenjar getah bening)
Bahasa Indonesia: NGS
pengurutan generasi berikutnya
Bahasa Inggris NLS
sinyal lokalisasi nuklir
Sistem Operasi
kelangsungan hidup secara keseluruhan
PI3K
fosfatidilinositol-3 kinase
PIK3CA
fosfatidilinositol-4,5-bisfosfat 3-kinase subunit katalitik alfa
Pn
invasi perineural
PTM
modifikasi pasca-translasi
RSK
kinase ribosom S6
S102
serin pada posisi 102 (situs fosforilasi)
T
tumor (komponen stadium tumor primer)
TNM
tumor-node-metastasis (sistem penentuan stadium kanker)
ATAS-1
enzim topoisomerase1
TP53
protein tumor p53
UICC
Persatuan Pengendalian Kanker Internasional
Bahasa Indonesia: V
invasi vaskular
Sayuran dan Buah-buahan
faktor pertumbuhan endotel vaskular
YB-1
Protein pengikat kotak Y 1
1 Pendahuluan
Kanker kolorektal (CRC) merupakan kanker ketiga yang paling banyak didiagnosis dan penyebab kematian akibat kanker keempat di seluruh dunia. Biomarker molekuler bersifat spesifik untuk perubahan genetik atau biokimia yang dapat dideteksi dalam sel atau jaringan kanker pasien dan digunakan untuk membantu diagnosis, klasifikasi, dan prediksi perilaku kanker.
Onkogen KRAS adalah biomarker molekular umum, yang bermutasi pada sekitar 45% CRC [ [ 1 ] ] dan telah dikaitkan dengan resistensi terhadap pengobatan tertentu [ [ 2 , 3 ] ]. KRAS, melalui beberapa kaskade pensinyalan di antaranya jalur MAPK/ERK dan PI3K/AKT, memediasi proliferasi sel tumor, kelangsungan hidup, perbaikan DNA, dan migrasi pada CRC [ [ 4 ] ]. Biomarker molekular yang telah diidentifikasi pada CRC meliputi reseptor faktor pertumbuhan epidermal (EGFR), faktor pertumbuhan endotel vaskular (VEGF), dan status ketidakstabilan mikrosatelit (MSI), yang merupakan indikator mekanisme perbaikan DNA pada sel kanker. Penanda prognostik dan prediktif tambahan dari CRC adalah mutasi TP53, PIK3CA , dan BRAF [ [ 2 ] ]. Berdasarkan penanda molekuler yang telah didefinisikan sejauh ini, pengobatan saat ini melibatkan pendekatan multimodal, seperti pembedahan dan kemoradioterapi (neo-)adjuvan (CRT), kemoterapi (CT), dan terapi molekuler yang ditargetkan. Regimen CT sering kali mengandung agen sitotoksik yang dikombinasikan dengan pendekatan penargetan molekuler, misalnya , terapi molekuler yang ditargetkan anti-EGFR atau anti-VEGF tergantung pada status mutasi KRAS, BRAF, NRAS , dan PIK3CA . Tumor bermutasi MSI dan BRAF V600E sering kali diobati dengan penghambat titik pemeriksaan dan/atau penghambat tirosin kinase.
Protein pengikat Y-box 1 (YB-1) adalah onkoprotein multifungsi yang terlibat dalam pengembangan dan pemeliharaan berbagai entitas kanker, termasuk namun tidak terbatas pada kanker payudara, kolorektal, dan paru-paru [ [ 5 – 8 ] ]. Dalam kondisi tertentu, YB-1 mengalami beberapa modifikasi pascatranslasi (PTM) yang dapat memengaruhi stabilitasnya, aktivitas transkripsi dan translasi, dan lokalisasi subseluler. Fosforilasi YB-1 pada S102 memainkan peran penting dalam afinitas pengikatannya terhadap DNA dan RNA, yang memengaruhi regulasi gen yang penting dalam perkembangan kanker [ [ 9 , 10 ] ].
Studi telah menunjukkan bahwa ekspresi YB-1 mempromosikan ekspresi beberapa onkogen dalam CRC dengan mengatur transkripsi gen kunci yang terlibat dalam perkembangan siklus sel, angiogenesis, dan metastasis [ [ 11 ] ]. Selain itu, YB-1 memengaruhi mekanisme perbaikan kerusakan DNA, berpotensi berkontribusi terhadap resistensi terhadap CRT dengan meningkatkan gen perbaikan DNA [ [ 10 , 12 , 13 ] ]. YB-1 nuklir juga mengikat promotor reseptor resistensi multi-obat 1 (MDR1) pada stres genotoksis ( yaitu , pengobatan kemoterapi) dan dengan demikian terlibat dalam resistensi terapi in vitro [ [ 14 ] ]. Selain itu, YB-1 dapat langsung berinteraksi dengan beberapa protein perbaikan DNA, termasuk MSH2, Ku80, WRN, dan DNA polimerase delta, setelah kerusakan DNA yang diinduksi cisplatin [ [ 15 ] ].
Fosforilasi YB-1 pada S102 terutama diatur oleh jalur mitogen-activated protein kinase (MAPK)/extracellular signal-regulated kinase (ERK) dan phosphatidylinositol-3 kinase (PI3K)/AKT. Fosforilasi ini dapat diaktifkan baik setelah stimulasi komponen-komponen kaskade hulu melalui faktor-faktor eksternal, atau dapat difosforilasi secara konstitutif oleh mutasi komponen hulu seperti KRAS [ [ 11 ] ]. Telah ditunjukkan bahwa mutasi KRAS menyebabkan fosforilasi YB-1 konstan pada S102 dalam sel CRC [ [ 13 ] ]. Hal ini terbukti dimediasi melalui p90 ribosomal S6 kinase (RSK) dan AKT [ [ 10 , 13 , 16 ] ]. Penghambatan efektif fosforilasi YB-1 pada S102 dicapai dengan menargetkan bersama RSK dan AKT [ [ 13 , 16 ] ]. Seperti yang disebutkan sebelumnya, PTM memengaruhi translokasi YB-1 ke nukleus. Dalam konteks ini, YB-1 dapat ditranslokasi ke nukleus dalam kondisi tertentu, termasuk hipoksia [ [ 17 ] ], pengobatan cisplatin [ [ 18 ] ], dan iradiasi UV [ [ 19 ] ]. Namun, bukti yang terkumpul menunjukkan bahwa setelah iradiasi pengion (IR), fosforilasi YB-1 nuklir pada S102 terjadi di nukleus melalui translokasi kinasenya, yaitu RSK [ [ 20 ] ].
Sejalan dengan fungsi YB-1 dalam perbaikan DNA, hubungan antara ekspresi total YB-1 dan prognosis yang buruk telah diamati pada pasien dengan kanker kolorektal, hepatoseluler, paru-paru, payudara, prostat, ginjal, dan kandung kemih, serta melanoma dan osteosarkoma [ [ 21 – 33 ] ]. YB-1 dilaporkan diekspresikan secara kuat pada CRC dibandingkan dengan jaringan kolon normal [ [ 34 – 36 ] ]. Shiraiwa dkk. [ [ 33 ] ] melaporkan kelangsungan hidup keseluruhan dan bebas kekambuhan yang berkurang pada pasien CRC, yang menunjukkan ekspresi tinggi YB-1 dalam nukleus pada lebih dari 60% sampel pasien CRC stadium tiga yang diuji. Status fosforilasi YB-1 tidak dievaluasi dalam penelitian tersebut.
Sejauh ini, hanya dua penelitian lain yang secara khusus menyelidiki YB-1 terfosforilasi pada S102 dalam spesimen kanker. Satu penelitian difokuskan pada kanker payudara dan mencatat peningkatan S102 YB-1 pada tumor yang kambuh dan resistan terhadap terapi [ [ 37 ] ]. Penelitian lain oleh Kosnopfel et al. [ [ 32 ] ] difokuskan pada melanoma, menunjukkan bahwa fosforilasi S102 dari YB-1 meningkatkan lokalisasi nukleus in vitro . Menariknya, peningkatan YB-1 sitoplasma yang tidak terfosforilasi tampaknya meningkatkan EMT dan invasi sel melanoma dibandingkan dengan YB-1 terfosforilasi S102.
Mengingat nilai prognostik ekspresi YB-1, tidak ada penelitian yang mengevaluasi hubungan antara status fosforilasi YB-1 dan mutasi KRAS pada pasien CRC. Dalam penelitian saat ini, kami menyelidiki lokalisasi subseluler S102 YB-1 sehubungan dengan korelasinya dengan mutasi genetik yang relevan secara terapeutik, yaitu , mutasi pada KRAS dan BRAF yang terkait dengan faktor klinis lainnya. Data yang diperoleh menunjukkan bahwa YB-1 yang terfosforilasi S102 terdapat pada sebagian besar spesimen CRC di sitoplasma terlepas dari status mutasi KRAS . Namun, mutasi KRAS dan bukan mutasi BRAF yang menyebabkan akumulasi fosforilasi YB-1 di nukleus.
Mutasi KRAS dikaitkan dengan resistensi terhadap inhibitor EGFR dan terapi target lainnya pada CRC [ [ 3 ] ]. Mengidentifikasi S102 YB-1 sebagai efektor hilir pada entitas tumor ini pada spesimen manusia menawarkan strategi penargetan tidak langsung yang potensial untuk tumor mutan KRAS , menghindari tantangan inheren dalam menghambat langsung KRAS mutan itu sendiri. Ini memberikan wawasan molekuler baru ke dalam tumorigenesis yang didorong KRAS, mengidentifikasi biomarker potensial, dan membuka jalan terapi baru. Temuan ini mengatasi kesenjangan kritis dalam pemahaman kita tentang pensinyalan KRAS pada pasien dan dapat mengarah pada hasil yang lebih baik bagi pasien dengan subtipe molekuler CRC yang menantang ini.
2 Bahan dan Metode
2.1 Etika
Sampel pasien diambil sesuai dengan persetujuan umum yang diberikan oleh pasien; oleh karena itu, eksperimen dilakukan dengan persetujuan tertulis dari setiap subjek. Studi yang disajikan sesuai dengan dan sebelumnya diizinkan oleh komite etik (525/2020BO) dari Universitas Tuebingen. Eksperimen dilakukan sesuai dengan undang-undang Jerman dan Deklarasi Helsinki.
2.2 Sampel pasien dan populasi penelitian
Sampel pasien yang difiksasi formalin dan dibenamkan dalam parafin (FFPE) dari pasien CRC diperoleh dari biobank Fakultas Kedokteran Universitas Tuebingen. Sampel dikumpulkan dari pasien yang menjalani operasi di klinik universitas Tuebingen antara tahun 2019 dan 2021. Tiga puluh enam sampel tumor (13 laki-laki, 23 perempuan) dan 5 sampel jaringan normal disertakan dalam penelitian ini. Data klinis dan patologis yang sesuai diperoleh dari arsip klinik. Usia rata-rata pasien saat onset adalah 69 tahun. Sebagian besar sampel ternyata berasal dari pasien dengan UICC Stadium III/IV, dengan rentang luas mengenai stadium TNM, yang tersedia untuk 35 pasien (Tabel 1 ).
Tabel 1. (A, B) Karakteristik populasi penelitian dan (C) frekuensi mutasi yang diamati.

2.3 Ekstraksi DNA dan sekuensing generasi berikutnya
DNA genom diekstraksi menggunakan Maxwell ® RSC DNA FFPE Kit dan Maxwell ® RSC Blood Kit, dan instrumen Maxwell ® RSC (Promega, Madison, WI, AS) sesuai dengan petunjuk pabrik.
Penyaringan mutasi multigen yang ditargetkan dilakukan oleh Next-Generation Sequencing (Ion GeneStudio S5, Thermo Fisher Scientific, Waltham, MA, AS) menggunakan AmpliSeq Colon and Lung Cancer Panel v2 (wilayah hotspot dalam 22 gen: KRAS, EGFR, BRAF, PIK3CA, AKT1, ERBB2, PTEN, NRAS, STK11, MAP2K1, ALK, DDR2, CTNNB1, MET, TP53, SMAD4, FBXW7, FGFR3, NOTCH1, ERBB4, FGFR1, FGFR2 ). Persiapan pustaka amplikon dan sekuensing semikonduktor dilakukan menurut manual pabrik menggunakan Ion AmpliSeq Library Kit v2.0, Ion Library TaqMan Quantitation Kit pada LightCycler 480 (Roche, Basel, Swiss), Ion 510 & Ion 520 & Ion 530 Kit—Chef pada Ion Chef, dan Ion 540 Kit-Chef (Thermo Fisher Scientific). File keluaran dibuat dengan Torrent Suite 5.16. Pemanggilan varian varian somatik non-sinonim dibandingkan dengan sekuens referensi manusia hg19 dilakukan menggunakan Ion Reporter Software (Thermo Fisher Scientific, versi 5.18). Ambang deteksi ditetapkan pada frekuensi alel 5%. Varian yang dipanggil oleh Ion Reporter Software divisualisasikan menggunakan Integrative Genomics Viewer (IGV; Broad Institute, Cambridge, MA, AS; Versi 2.11.9) untuk mengecualikan artefak khusus panel. Basis data NCBI dbSNP (termasuk GnomAD, ExAC, dan TOPMED) digunakan untuk mengecualikan SNP.
2.4 Pewarnaan imun
Untuk pewarnaan imunofluoresensi, irisan parafin dideparafinisasi dan dihidrasi ulang. Kaca objek diinkubasi dalam buffer EDTA pH 9,0 (Zytomed, Berlin, Jerman) menggunakan penanak uap. Irisan diblokir menggunakan serum keledai (Sigma-Aldrich, #F9663, St. Louis, MO, AS) dan diinkubasi dengan antibodi berikut: anti-YB-1 tikus (Abcam, #ab268094, Cambridge, Inggris Raya) dan anti-P-YB-1 kelinci (Cell Signaling, #2900, Leiden, Belanda). Antibodi terikat divisualisasikan menggunakan anti-mouse-Alexa-647 keledai (Dianova, #715-606-151, Hamburg, Jerman) dan anti-kelinci-Cy3 keledai (Dianova, #711–166-152). YO-PRO-1 (Thermo Fisher Scientific, #Y3603) digunakan untuk pewarnaan nuklir. Potongan dianalisis menggunakan mikroskop pemindai laser confocal LSM 800 (Zeiss, Oberkochen, Jerman). Gambar diproses dengan perangkat lunak ZEN 2.3 (edisi biru).
Untuk melakukan pewarnaan imunohistokimia, setelah fiksasi dalam formalin 4%, jaringan didehidrasi, ditanamkan dalam parafin, dipotong menjadi bagian-bagian 3 μm, dideparafinisasi, dan diwarnai dengan hematoxylin dan eosin (HE). Imunohistokimia (IHC) dilakukan dengan anti-P-YB-1 S102 kelinci (Cell Signaling, #2900) pada imunopewarna otomatis (Leica Bond-MAX; Leica Biosystems, Wetzlar, Jerman) sesuai dengan protokol perusahaan. Slide kemudian didigitalisasi menggunakan pemindai slide digital (NanoZoomer 2.0-HT; Hamamatsu Photonics KK, Hamamatsu, Jepang) dan dianalisis menggunakan NDP.view2. Untuk membuat stratifikasi intensitas pewarnaan fosforilasi YB-1 pada S102, slide yang diwarnai dianalisis oleh dua orang ahli dan diklasifikasikan ke dalam empat kelompok berdasarkan intensitas pewarnaan.
2.5 Analisis Statistik
Data dianalisis menggunakan perangkat lunak IBM SPSS Statistics 28. Data kategorikal dilaporkan sebagai angka dan persentase; data kontinu diringkas dengan rata-rata atau dengan median dalam distribusi miring. Untuk menggambarkan hubungan antara dua variabel kategorikal, tabulasi silang digunakan. Berkaitan dengan ukuran sampel yang terbatas, uji independensi eksak Fisher dilakukan untuk analisis tabel 2 × 2. Untuk membandingkan proporsi berpasangan, uji McNemar digunakan. Grafik dan tabel dibuat menggunakan IBM SPSS Statistics, Microsoft Excel, dan Serif Affinity Designer.
3 Hasil
3.1 Stratifikasi intensitas pewarnaan fosforilasi YB-1 pada S102
Intensitas pewarnaan imunohistokimia S102 YB-1 dikuantifikasi secara semikuantifikasi dalam nukleus dan sitoplasma (Gbr. 1 ). Fosforilasi YB-1 pada pewarnaan S102 dalam sitoplasma dinilai sebagai (0) = tanpa pewarnaan, (+) = <25% sel dengan S102, (1+) = <75% sel dengan S102, (2+) = >75% sel dengan S102 di daerah tumor (Gbr. 1A ). Selain itu, pewarnaan nukleus S102 YB-1 juga dikelompokkan lagi (Gbr. 1B ). Dalam pewarnaan imunohistokimia dan imunofluoresensi gabungan, area tumor menunjukkan sinyal tinggi untuk YB-1 dan S102 YB-1 (Gbr. 2A,B ) dan pada tingkat subseluler, sinyal S102 YB-1 dapat dibedakan dari sinyal YB-1 total (Gbr. 2C–E ). Berdasarkan mikroskopi, tiga bentuk sel kanker dapat diidentifikasi: sinyal S102 YB-1 tinggi dalam sitoplasma dan nukleus secara bersamaan, sinyal S102 YB-1 tinggi hanya dalam sitoplasma, dan sinyal S102 YB-1 rendah secara keseluruhan (Gbr. 2C–E ).

Gbr. 1
Buka di penampil gambar
Kekuatan Gambar
Demonstrasi intensitas pewarnaan imunohistokimia S102 YB-1 dalam sistem semikuantitatif di (A) sitoplasma (0 ( n = 1), (+) ( n = 14), 1+ ( n = 11), 2+ ( n = 10)) dan (B) nukleus (− ( n = 19), + ( n = 17)). Skala batang 25 μm. Pembesaran asli ×400.

Gambar 2
Buka di penampil gambar
Kekuatan Gambar
Pewarnaan subseluler fosforilasi YB-1 pada jaringan pasien CRC ( n = 36). (A, B) Pewarnaan imunohistokimia dan imunofluoresensi. Pembesaran asli ×50 (gambar kiri atas). (C) Pewarnaan negatif fosfo-YB-1 dalam sitoplasma dan dalam nukleus ( n = 1). (D) Pewarnaan positif S012 YB-1 (P-YB-1) dalam sitoplasma tetapi tidak dalam nukleus ( n = 18). (E) Pewarnaan positif P-YB1 baik dalam sitoplasma maupun nukleus ( n = 17). Biru = AF647 (total YB-1), Merah = Cy3 (S102 P-YB1), Hijau = YoPro1 (nukleus).
3.2 Analisis mutasi pada sampel yang diteliti
Karakteristik kohort dirangkum dalam Tabel 1A–C . Kohort studi menunjukkan sebagian besar kanker stadium tinggi (UICC III dan IV), dan sebagian besar spesimen adalah CRC sisi kanan dan CRC sigmoid (Tabel 1A,B ). Untuk mempelajari dampak mutasi KRAS pada fosforilasi YB-1 pada S102, dilakukan pengurutan generasi berikutnya (NGS). Selain mutasi KRAS , status mutasi gen yang telah dilaporkan sering bermutasi pada CRC dianalisis (Tabel 1C ). Di antara gen yang dianalisis, TP53 adalah gen yang paling sering bermutasi yang diamati, diikuti oleh mutasi KRAS pada 40,5% sampel. Mutasi pada KRAS hadir dalam 44% sampel kolon kanan dan 42% sampel kolon kiri. Di antara mutasi KRAS yang diamati , mutasi yang paling sering terjadi adalah pada kodon 12 dan 13 ekson 2 (G12/G13) dalam 87% dari semua sampel yang bermutasi KRAS . Mutasi KRAS pada kodon 61 (Q61C) terdeteksi dalam 2 sampel. Mutasi BRAF , yang saling eksklusif dengan mutasi KRAS , ditemukan dalam 24,3% sampel. Mutasi F-box dan WD repeat domain-containing 7 (FBXW7 ) terdeteksi dalam sekitar 10% sampel CRC. Frekuensi semua mutasi gen lain yang terdeteksi oleh panel yang digunakan dirangkum dalam Tabel 1C .
3.3 Distribusi subseluler YB-1 terfosforilasi
Area karsinomatosa dalam sampel menunjukkan intensitas pewarnaan yang kuat dari S102 fosfo-YB-1 (Gbr. 3A,B ). Sebaliknya, dalam sebagian besar sampel, area dengan mukosa normal negatif untuk fosforilasi S102 dari YB-1 (contohnya ditunjukkan pada Gbr. 3C ). Sejalan dengan pengamatan ini, tidak ada sampel jaringan normal yang disertakan ( n = 6) yang menunjukkan fosforilasi S102 YB-1 dalam sitoplasma atau nukleus. S102 YB-1 nukleus hanya ada dalam sampel yang menunjukkan S102 YB-1 dalam sitoplasma. Secara total, 1 sampel tumor dan 6 sampel jaringan normal negatif untuk S102 YB-1 dalam sitoplasma, yang semuanya juga negatif untuk S102 YB-1 dalam nukleus. Di antara sampel CRC yang dianalisis, 47,2% menunjukkan fosforilasi YB-1 dalam nukleus dan sitoplasma, secara bersamaan (Gbr. 3D ).

Gambar 3
Buka di penampil gambar
Kekuatan Gambar
Pewarnaan fosforilasi YB-1 pada jaringan pasien CRC. (A) Pewarnaan IHC representatif dari intensitas pewarnaan YB-1 terfosforilasi pada S102 pada mukosa normal vs. adenokarsinoma pada pasien yang sama. (B, C) Ringkasan tabel silang yang menunjukkan ekspresi S102 YB-1 dalam sitoplasma vs. nukleus pada jaringan kanker (B) dan jaringan normal (C) yang termasuk dalam penelitian ini. (D) Representasi relatif fraksi S102 YB-1-negatif dan positif dari sampel.
3.4 Hubungan antara kadar S102 YB-1 dengan parameter patologi klinik dan molekuler pada pasien kanker kolorektal
Distribusi lokalisasi CRC dalam populasi studi disajikan dalam Gambar 4A . Di antara distribusi, mutasi KRAS yang berhubungan dengan S102 yang terfosforilasi YB-1 terutama diamati pada tumor yang terlokalisasi di kolon desendens, sigmoid, dan rektum (Gambar 4A ). Pada tumor dari area ini, status positif S102 YB-1 nuklir secara signifikan terkait dengan status bermutasi KRAS ( P = 0,017) (Gambar 4B,C ). Mutasi KRAS menyebabkan peningkatan fosforilasi YB-1 nuklir di S102. Seperti yang digambarkan dalam Gambar 4A , keberadaan S102 YB-1 dalam nukleus dan mutasi KRAS saling tumpang tindih. Yang paling menarik, ada kebetulan yang lebih kuat dari mutasi KRAS dan fosforilasi YB-1 di kolon kiri (kolon desendens, sigmoid, rektum) di mana 60% tumor bermutasi KRAS (Gbr. 4A ). Di antara mereka, 80% menunjukkan nilai tinggi S102 YB-1 ( P = 0,072 untuk asosiasi). Status mutasi KRAS tidak terkait dengan peningkatan fosforilasi YB-1 dalam fraksi sitoplasma (Tabel 2 ). Populasi studi juga menunjukkan bahwa – sementara mutasi KRAS dan BRAF saling eksklusif – kemungkinan S102 YB-1 nuklir berkurang dalam sampel bermutasi BRAF dibandingkan dengan sampel tipe liar dengan asosiasi negatif yang tidak signifikan ( P = 0,128) (Gbr. 4D ). Tidak ada asosiasi yang diamati antara mutasi TP53, PIK3Ca , dan SMAD4 dan fosforilasi nuklir YB-1. Menariknya, mutasi FBXW7 berkorelasi signifikan dengan keberadaan nuklir S102 YB-1 ( P = 0,04) (Tabel 2 ).

Gambar 4
Buka di penampil gambar
Kekuatan Gambar
Hubungan antara kadar S102 YB-1 dan mutasi KRAS/BRAF , serta parameter klinikopatologi tambahan, pada pasien CRC. (A) Distribusi lokalisasi CRC dalam populasi studi (area abu-abu). Proporsi relatif mutasi KRAS/BRAF dan P-YB-1 nuklir pada lokasi yang ditunjukkan di kolon ( n = 36). (B) Grafik batang yang menunjukkan jumlah relatif sampel dengan P-YB-1 nuklir yang bergantung pada status mutasi KRAS/BRAF ( mut KRAS n = 15, wt n = 12, mut BRAS n = 9). (C, D) Grafik batang yang menunjukkan jumlah absolut kasus dengan dan tanpa P-YB-1 nuklir, bergantung pada status mutasi KRAS (C) dan status mutasi BRAF (D) ( n = 36). (E, F) Dampak stadium TNM, status mikrosatelit, gradasi, dan invasi limfangioma/vaskular pada status fosforilasi YB-1. Grafik batang menunjukkan proporsi sampel dengan P-YB1 nuklir dalam tahap T2–4 (E), subkelompok N0, N1, dan N2 (E), subkelompok M0 dan M1, subkelompok MSS dan MSI-Tinggi, subkelompok G2 dan G3 (F), subkelompok L0 dan L1, subkelompok V0 dan V1 (F) pada intensitas YB-1 terfosforilasi dalam nukleus. (G) Grafik batang yang menunjukkan proporsi S102 YB-1 dalam nukleus dan sitoplasma dalam tahap UICC I–IV (G) ( n = 36). mut, bermutasi; ns, tidak signifikan; wt, tipe liar. Untuk analisis statistik (B–G), uji pasti Fisher diterapkan.
Tabel 2. Karakteristik populasi studi yang dikelompokkan berdasarkan S102 nukleus dan sitoplasma. Jenis kelamin populasi studi, lokasi CRC primer, stadium TNM (T = Tumor; N = Node; M = Metastasis), serta penanda histopatologis untuk invasi limfovaskular (LVI), invasi vaskular (V) dan invasi perineural (Pn), serta stadium UICC. Gen panel terpilih dianalisis dalam uji pan-tumor Archer, serta status mikrosatelit yang dikelompokkan berdasarkan keberadaan S102 dalam nukleus dan sitoplasma. Persentase baris lapisan dihitung untuk menggambarkan distribusi di antara sampel. Usia median onset tumor, kelangsungan hidup bebas penyakit (DFS) dan kelangsungan hidup keseluruhan (OS) digambarkan dengan interval kepercayaan atas dan bawah (CI) 95% yang sesuai. Nilai- P seperti yang dihitung dengan uji Fisher’s Exact 2-sided digambarkan di sebelah parameter yang dianalisis. Asosiasi yang signifikan ditandai dengan warna hijau tua. Mut, bermutasi; na, tidak tersedia; Wt, tipe liar.

Secara keseluruhan, tidak ditemukan korelasi signifikan antara stadium UICC dan S102 YB-1 sitoplasma atau nuklir; namun, perlu diperhatikan bahwa S102 YB-1 nuklir tampaknya kurang hadir pada stadium UICC yang lebih tinggi (III/IV) (Gbr. 4G , Tabel 2 ).
Selain itu, kami menyelidiki dampak status mikrosatelit, invasi limfovaskular (LVI), stadium TNM, dan grading pada status fosforilasi YB-1 nuklir (T = Tumor; N = Node; M = Metastasis). Dibandingkan dengan tumor mikrosatelit stabil (MSS, n = 28), CRC dengan ketidakstabilan mikrosatelit tinggi (MSI-Tinggi, n = 8) ditemukan memiliki kemungkinan lebih tinggi untuk mengekspresikan S102 YB-1 nuklir (Gbr. 4F , Tabel 2 ); namun, ini tidak signifikan secara statistik. Ada tren negatif antara S102 YB-1 nuklir dan LVI (tidak signifikan, P = 0,092) (Gbr. 4E , Tabel 2 ). Tren juga diamati antara S102 YB-1 dalam nukleus dan usia onset tumor yang lebih muda (tidak signifikan, P = 0,075) (Tabel 2 ). Tidak ada hubungan signifikan yang diamati dengan T-staging atau grading. Namun, dicatat bahwa tumor G3 lebih mungkin mengekspresikan S102 YB-1 dalam sitoplasma daripada tumor G2, meskipun ini tidak signifikan secara statistik ( P = 0,092) (Gbr. 4F , Tabel 2 ). Tidak ada hubungan antara invasi vaskular (V), invasi perineural (Pn), dan metastasis umum (M-Stage) dengan fosforilasi YB-1 pada S102 (Gbr. 4E,F , Tabel 2 ). Ada pengurangan signifikan dalam proporsi pasien dengan metastasis kelenjar getah bening ( P = 0,043) ketika S102 YB1 hadir dalam nukleus (Gbr. 4E , Tabel 2 ). Tidak ditemukan korelasi dengan metastasis hati (Tabel 2 ).
4 Diskusi
Secara luas diasumsikan bahwa YB-1 perlu diaktifkan melalui fosforilasi untuk memediasi efek onkogeniknya pada ciri khas kanker, khususnya pada kanker kolorektal [ [ 13 ] ]. Diasumsikan bahwa YB-1 ditransfer ke nukleus ketika tidak difosforilasi, dan bahwa fosforilasi kemudian menyebabkan retensi sitoplasma atau nuklir. Di kedua kompartemen, kinase s6 ribosomal (RSK) terlibat dalam fosforilasi S102 YB-1 [ [ 20 , 38 ] ]. Dalam penelitian ini, S102 YB-1 nuklir terdeteksi pada 47,2% sampel, sedangkan S102 YB-1 sitoplasma diamati pada semua sampel kecuali satu.
Sementara YB-1 terutama berada di sitoplasma, keterlibatannya dalam regulasi transkripsi dan translasi memungkinkannya ditemukan di kedua kompartemen [ [ 39 ] ]. Dalam kondisi tertentu seperti respons stres dan resistensi obat, YB-1 dapat ditranslokasi ke nukleus [ [ 39 ] ]. Khususnya, PTM memainkan peran penting dalam mengatur translokasi YB-1 ke nukleus dengan menginduksi perubahan konformasi yang dapat mengekspos urutan sinyal lokalisasi nuklir (NLS). Dalam studi in vitro , mutasi KRAS telah terbukti meningkatkan fosforilasi YB-1 pada S102 pada kanker payudara dan CRC [ [ 10 , 13 , 20 ] ] tanpa menginduksi translokasi YB-1 ke nukleus [ [ 20 ] ]. Di sini kami memeriksa status fosforilasi YB-1 pada S102 dalam sitoplasma dan nukleus secara berbeda ex vivo dalam jaringan CRC dari 36 pasien dan dampak mutasi genetik pada lokalisasi subseluler. Frekuensi mutasi umum gen yang diamati sebanding dengan yang dipublikasikan sebelumnya [ [ 1 , 40 , 41 ] ].
Studi ini dapat menunjukkan bahwa S102 YB-1 nuklir dikaitkan secara signifikan dengan status mutasi KRAS , tetapi tidak berkorelasi dengan status mutasi BRAF . Korelasi signifikan tambahan diamati antara keberadaan S102 YB-1 di nuklir dan mutasi FBXW7 .
Studi kami tidak menunjukkan hubungan signifikan antara S102 YB-1 dan stadium serta tingkat tumor, meskipun S102 YB-1 nuklir lebih sering terjadi pada tumor tingkat tinggi. Studi lain telah mencatat korelasi ekspresi YB-1 nuklir dan sitoplasma dengan neoplasia tingkat tinggi pada kanker Kepala dan Leher [ [ 42 ] ] dan CRC [ [ 36 ] ].
Tidak ada hubungan kuat yang dapat ditemukan antara parameter klinikopatologi seperti MSI-H dan stadium UICC. Studi yang sedang dilakukan tidak melihat adanya hubungan signifikan antara S102 nuklir YB-1 dan Stadium-M. Menariknya, studi kami menemukan korelasi negatif signifikan antara S102 nuklir dan metastasis limfonodal (Stage-N). Menariknya, Kosnopfel et al. [ [ 32 ] ] menunjukkan pada spesimen melanoma bahwa YB-1 meningkatkan invasi dan metastasis hanya dalam bentuk S102 yang tidak terfosforilasi. Tidak ada studi lain yang mengevaluasi YB-1 yang terfosforilasi secara eksplisit dalam penyebaran metastasis dan sejauh ini, kesimpulan utama hanya ditarik untuk ekspresi YB-1 total. Studi sebelumnya pada pasien CRC menunjukkan bahwa ekspresi YB-1 mungkin terkait dengan invasi limfovaskular dan metastasis kelenjar getah bening [ [ 29 ] ]. Sebuah studi serupa pada kanker lambung telah menunjukkan bahwa ekspresi YB-1 secara signifikan terkait dengan penyebaran kelenjar getah bening [ [ 43 ] ]. Sebaliknya, Ardito et al. [ [ 44 ] ] memeriksa 66 Pasien CRC dan tidak menemukan korelasi signifikan antara ekspresi YB-1 total dan faktor prognosis klinis, seperti stadium N. Peran S102 YB-1 dalam penyebaran limfatik belum jelas dan diperlukan penelitian lebih lanjut untuk menguraikan subjek ini. Keterlibatan YB-1 dalam modulasi gen yang terkait dengan metastasis dan perannya dalam mendorong angiogenesis dapat berperan dalam hubungan ini. Namun, modulator ini belum diketahui.
Tidak banyak yang dilaporkan mengenai korelasi mutasi YB-1 dan BRAF . Secara umum diasumsikan bahwa YB-1 difosforilasi melalui AKT dan RSK [ [ 13 , 16 ] ]. RSK adalah kinase hilir dari BRAF, jadi pengaktifan mutasi BRAF seharusnya secara mekanistis meningkatkan S102 YB-1. Namun, tampaknya tidak sesederhana itu. Penelitian yang ada adalah yang pertama mengevaluasi hubungan ini secara eks vivo dan menemukan bahwa S102 YB-1 tidak berkorelasi dengan mutasi BRAF pada CRC dengan cara yang sama seperti mutasi KRAS . Peran BRAF pada CRC sangat berbeda dari entitas tumor lainnya, yaitu , monotarget BRAF tidak efektif pada CRC dan memerlukan penargetan EGFR tambahan untuk menegaskan efek anti-tumor [ [ 45 , 46 ] ].
Studi yang sedang dilakukan adalah yang pertama kali menemukan hubungan antara mutasi S102 YB-1 dan FBXW7 . Pada CRC, mutasi pada FBXW7, penekan tumor, terlibat dalam jalur pensinyalan onkogenik [ [ 47 ] ]. FBXW7 menargetkan berbagai protein untuk degradasi yang dimediasi ubiquitin, dan mutasi FBXW7 menginduksi aktivitas mTOR (target mekanistik rapamycin), dan aktivasi oleh kompleks mTOR dapat memengaruhi fosforilasi YB-1 [ [ 48 , 49 ] ].
Ardito et al. [ [ 44 ] ] menunjukkan bahwa ekspresi YB-1 sitoplasma hadir dalam semua kasus CRC dan ekspresi YB-1 yang kuat adalah satu-satunya faktor risiko independen untuk memprediksi peningkatan kekambuhan CRC. Studi klinis terkini yang menyelidiki dampak ekspresi YB-1 pada hasil terapi pada pasien kanker payudara, serviks, kepala dan leher, serta sarkoma, mengidentifikasi ekspresi YB-1 nuklir sebagai faktor prognostik negatif untuk OS, kelangsungan hidup bebas penyakit, atau kelangsungan hidup bebas progresi [ [ 22 , 42 , 50 – 52 ] ]. Kami merekomendasikan stratifikasi dengan tipe liar BRAF dalam kelompok yang lebih besar untuk evaluasi masa depan peran prognostik S102 YB-1, karena mutasi BRAF ditentukan menjadi salah satu mutasi utama yang relevan secara prognostik dalam CRC [ [ 53 , 54 ] ]. Selain itu, berdasarkan pengamatan bahwa hampir semua sampel CRC dalam penelitian ini positif untuk S102 YB-1, kami merekomendasikan S102 YB-1 nuklir sebagai penanda yang lebih terdiferensiasi untuk analisis kelangsungan hidup lebih lanjut dalam kelompok yang lebih besar. Karena ukuran sampel yang terbatas, analisis kelangsungan hidup tidak dilakukan dalam penelitian ini.
Segmen diskusi berikut akan berputar di sekitar peran mutasi KRAS dan fosforilasi YB-1 S102 berturut-turut dalam respons kemoterapi. Secara umum, YB-1 telah terbukti meningkatkan ekspresi gen yang terlibat dalam resistensi kemoterapi, termasuk gen perbaikan DNA seperti XRCC1, BRCA1 [ [ 55 ] ] dan gen MDR ABCB1 , yang mengkode untuk glikoprotein P [ [ 14 , 56 , 57 ] ]. Selain itu, dalam sel CRC, ditunjukkan bahwa YB-1 memediasi ekspresi protein kubah utama (MVP), yang juga diduga bertanggung jawab atas MDR pada kanker [ [ 58 , 59 ] ].
Dalam konteks ini, 5-Fluorouracil (5-FU), yang merupakan bagian utama dari regimen kemoterapi lini pertama pada CRC, menginduksi pengikatan YB-1 ke promotor MVP yang berpotensi meningkatkan MDR bahkan pada sel tanpa ekspresi YB-1 yang didorong oleh mutasi [ [ 57 ] ]. Memblokir fosforilasi YB-1 melalui penargetan kinase hulu menyebabkan peningkatan sensitivitas terhadap 5-FU pada sel CRC [ [ 13 ] ]. Selain itu, sebuah penelitian oleh Tsofack et al. [ [ 60 ] ] telah menunjukkan bahwa ekspresi berlebihan YB-1 menyebabkan resistensi oksaliplatin pada lini sel CRC manusia.
Oleh karena itu, kita dapat menyimpulkan dari percobaan in vitro bahwa CRC dengan kadar YB-1 terfosforilasi tinggi berisiko mengalami resistensi terapi terhadap 5-FU dan oksaliplatin, dan bahwa memblokir fosforilasi YB-1 mungkin merupakan strategi terapi yang menjanjikan.
Irinotecan, yang sangat penting dalam pengobatan CRC dan sering menjadi bagian dari regimen terapi awal ( misalnya , FOLFIRI). Khasiat penghambat topoisomerase 1 (TOP-1) telah menunjukkan selektivitas yang lebih tinggi terhadap sel CRC bermutasi KRAS [ [ 61 ] ]. Lebih jauh lagi, telah ditunjukkan bahwa YB-1 berinteraksi dengan TOP-1 dan meningkatkan aktivitasnya [ [ 62 , 63 ] ]. Pembentukan kompleks ini menyebabkan peningkatan sensitivitas terhadap penghambat TOP-1, camptothecin [ [ 62 ] ]. Mengingat korelasi yang diamati antara mutasi KRAS dan fosforilasi nuklir YB-1, dapat dihipotesiskan bahwa dalam sel kanker bermutasi KRAS , peningkatan aktivitas YB-1 dapat berperan dalam peningkatan sensitivitas terhadap irinotecan (turunan camptothecin).
Yang paling menarik, melihat studi klinis yang mengelompokkan hasil pengobatan berbasis oksaliplatin dan irinotecan berdasarkan status mutasi KRAS , dilaporkan bahwa CRC bermutasi KRAS merespons lebih buruk terhadap rejimen berbasis oksaliplatin dibandingkan dengan CRC tipe liar KRAS [ [ 64 , 65 ] ]. Namun, dalam pengobatan klinis CRC, saat ini, status mutasi KRAS terutama dilihat untuk memutuskan apakah terapi yang menargetkan EGFR layak dilakukan. Pengamatan ini divalidasi oleh ekspresi EGFR yang berkurang dalam sel CRC setelah penurunan YB-1 [ [ 66 ] ]. Dengan demikian, pengobatan dengan antibodi yang menargetkan EGFR (cetuximab, panitumumab) dapat diasumsikan lebih efisien pada spesimen dengan ekspresi YB-1 yang tinggi. Sebaliknya, dapat juga dikatakan bahwa S102 YB-1 tinggi yang berasal dari mutasi aktivasi hulu (KRAS, MEK, ERK, PI3K) juga dapat meniadakan efek penargetan EGFR yang mirip dengan mutasi KRAS . Telah ditunjukkan bahwa pengurangan fosforilasi YB-1 meningkatkan efek cetuximab in vitro pada sel CRC [ [ 13 ] ], yang mungkin merupakan pendekatan yang menjanjikan pada CRC bermutasi KRAS yang secara intrinsik tidak merespons dengan baik terhadap terapi yang menargetkan EGFR.
Hal ini dapat berdampak pada pemilihan dan penerapan terapi, misalnya , menggunakan inhibitor topoisomerase irinotecan sebagai pengganti oksaliplatin dan terapi berbasis VEGF sebagai pengganti terapi berbasis EGFR pada spesimen S102 YB-1 yang tinggi. Untuk penyederhanaan, penelitian ini telah menunjukkan korespondensi yang tinggi antara S102 YB-1 nuklir dan mutasi KRAS —dengan demikian, asumsi yang relevan secara terapeutik ini juga dapat ditransfer ke kanker yang bermutasi KRAS .
Meskipun penelitian ini memberikan wawasan mengenai lokalisasi subseluler YB-1, khususnya yang berkaitan dengan fosforilasi S102, ada beberapa keterbatasan penting yang perlu dipertimbangkan, khususnya mengenai ukuran sampel, kendala metodologis, dan implikasi fungsional. Namun, dengan mengatasi keterbatasan ini dalam penelitian mendatang—melalui ukuran sampel yang lebih besar, uji fungsional, dan teknik pencitraan dinamis—penelitian ini dapat memberikan dampak substansial pada biologi kanker dan pemahaman tentang modifikasi pascatranslasi pada kanker dan relevansi klinisnya. Akibatnya, dengan menentukan status fosforilasi, bukan hanya status ekspresi, YB-1 pada sampel pasien, kami dapat menunjukkan korelasi signifikan antara mutasi KRAS dan fosfo-YB-1 S102 nuklir. Berbeda dengan penelitian sebelumnya, kami dapat membuktikan bentuk aktif YB-1 ini hadir dalam nukleus CRC pada pasien. S102 YB-1 nuklir khususnya hadir dalam spesimen metastasis non-limfonodal. Selain itu, kami menemukan korelasi signifikan dari mutasi FBXW7. Penelitian lebih lanjut diperlukan.
5 Kesimpulan
Kami telah menyelidiki kohort pasien CRC mengenai status fosforilasi YB-1 dan membedakan lokalisasi subselulernya. Meskipun hubungan antara mutasi KRAS dan fosforilasi YB-1 pada S102 telah diselidiki secara ekstensif in vitro , hubungan antara fosforilasi YB-1 dan lokalisasi subseluler, dan mutasi KRAS dalam jaringan CRC ex vivo masih harus dijelaskan. Sejauh pengetahuan kami, ini adalah studi pertama yang menyelidiki hal ini. Kami juga secara luas mengeksplorasi apakah ada aspek klinikopatologis yang terkait dengan S102 nuklir YB-1 dan menemukan bahwa selain mutasi KRAS , mutasi FBXW7 , dan metastasis kelenjar getah bening terkait dengan status fosforilasi YB-1.
Dengan menentukan tingkat nuklir S102 YB-1 dalam sampel CRC, mungkin saja untuk mengidentifikasi pasien yang berisiko lebih tinggi terhadap perkembangan kanker. Selain itu, penentuan S102 YB-1 dalam sampel CRC memberikan wawasan berharga mengenai mekanisme dasar regulasi YB-1 dalam CRC dan membantu mengidentifikasi target terapi dan pengobatan potensial untuk penyakit ini. Di masa mendatang, fosfoproteomik kanker mungkin merupakan pendekatan yang menjanjikan untuk menargetkan jalur onkogenik pada pasien, serta alat prediktif untuk pemilihan terapi dan pemantauan respons.

